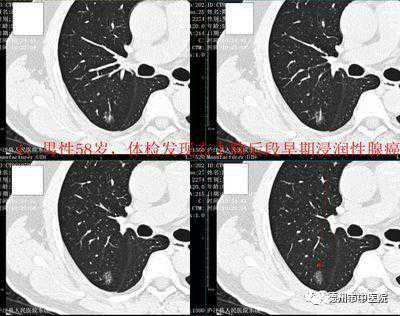

您现在的位置是:首页 > 牙齿美白知识
德州人看过来,这家医院口腔整形、白内障手术、CT筛查都有优惠活动
皓齿牙科网
2024-12-29【牙齿美白知识】36人已围观
简介日前,德州市中医院推出一系列优惠活动,包括口腔整形、白内障手术、CT筛查,下面就随小编往下看看吧。德州市中医院口腔科寒假“正畸美牙”活动开始了!期待已久的寒假终于来了!春节过年走亲访友,灿烂的笑容不可少,一口整齐漂亮的牙齿能让你更加自信美丽!可是牙齿排列不齐、有缝隙、歪歪斜斜、外凸、内陷、牙齿颜色发...
日前,德州市中医院推出一系列优惠活动,包括口腔整形、白内障手术、CT筛查,下面就随小编往下看看吧。

德州市中医院口腔科寒假“正畸美牙”活动开始了!
期待已久的寒假终于来了!春节过年走亲访友,灿烂的笑容不可少,一口整齐漂亮的牙齿能让你更加自信美丽!可是牙齿排列不齐、有缝隙、歪歪斜斜、外凸、内陷、牙齿颜色发黄、发灰……如何灿烂微笑?
据统计数据表明:牙齿不齐、牙齿颜色发黄发黑的人80%不愿张嘴大笑,甚至不愿在公共场合开口说话;50%的人想尽量避开社交场合或不愿参加社交活动;32%的人怀有自卑感。
德州市中医院口腔科邀请您,即时加入到正畸美牙保卫战的活动中,远离牙齿美观问题!给青春、给美好的生活带来灿烂的笑容,利用寒假的时间悄悄地变美。
优惠项目:
1免收牙齿正畸诊断设计费(原每病例应收350元)
2免收隐形正畸3D动画设计费(原每病例应收1000元)
3前牙美容全瓷贴面,后牙美容全瓷嵌体免费取模(咬牙印,原每副应收220元)
活动时间:
2020年1月9日——2月19日
活动地点:
东院区天衢东路1165号市中医院四楼西侧口腔科。电话:2725077
西院区东方红路461号市中医院门诊楼二楼西侧口腔科。电话:2220524
随着我国老龄化的加剧,老年性白内障患者群体越来越大,进入21世纪以来,白内障已成为我国第一大致盲眼病。

为推进防盲致盲工作,减轻广大白内障患者的经济负担,市中医院对白内障手术患者施行以下惠民政策:
1.因白内障疾病来诊的患者,免除眼科门诊相关检查费。
2.经检查及核对,对符合诊疗条件的白内障手术患者,免除部分手术费及检查费、材料费,患者最低仅自付200元。
3.手术患者三个月以内复查均免除检查费及治疗费。
东院区地址:德州市天衢东路1165号市中医院3楼眼科门诊咨询电话:
西院区地址:德州市东方红西路461号市中医院2楼眼科门诊咨询电话:联系人:徐红主任
自2020年1月11日起,德州市中医院西院区CT室开展检查优惠活动:
1、每周六全天门诊平扫患者实行半价收费(优惠后每部位200元),住院患者除外。
2、每天下午进行低剂量肺结节CT筛查(优惠后200元),适用于早期肺癌的筛查,在降低辐射剂量的前提下,为您的健康保驾护航。
地址:德州市东方红西路461号门诊楼一楼CT室咨询电话:2220529
什么是低剂量螺旋CT?低剂量螺旋CT是用最小的扫描范围,最低剂量,最少的X线量,对病变作出诊断。因为螺旋CT,常规一次扫描辐射量大概是3-5mSv,低剂量大概是1mSv,辐射量可以缩小2/3,对病变的检查也可以作出的准确的诊断。相比传统的常规CT检查,一个是剂量小,使病人受到辐射小,对微小结节也能够清楚地显示。常规用于体检或者肺部微小结节的追踪观察,这样使病人能够得到准确的诊断,然后又不接受更多剂量的X线。

编辑|石少军通讯员|王琰
很赞哦!(88)